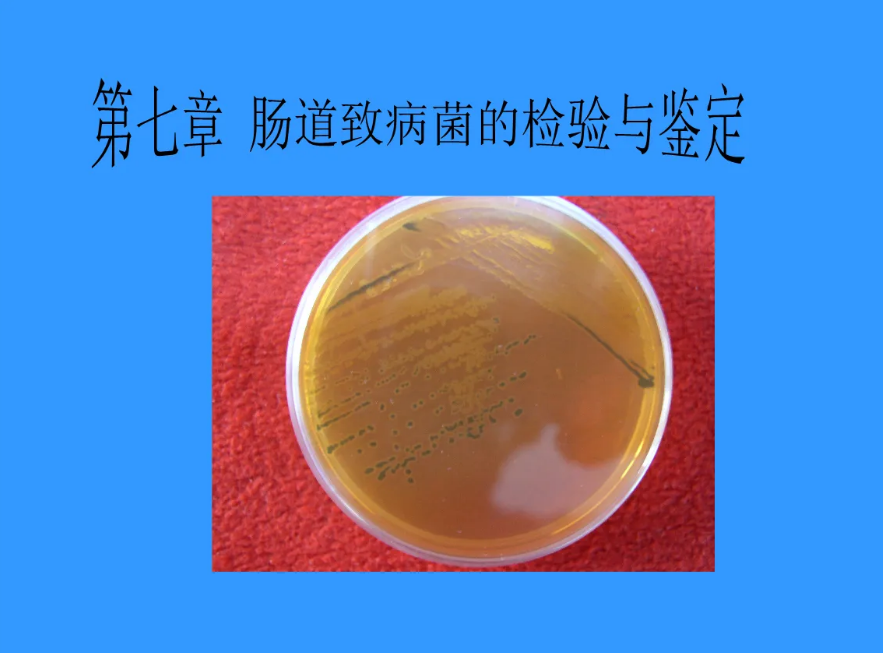
emb培养基是什么培养基

EMB培养基

大肠菌群用emb琼脂培养基(emb agar)
图片尺寸538x538
m0003伊红美蓝琼脂培养基emb曙红亚甲蓝琼脂250g杭州微生物
图片尺寸800x800
伊红美蓝琼脂培养基(emb)
图片尺寸800x800
曙红亚甲基蓝琼脂培养基emb
图片尺寸400x400
伊红美蓝琼脂250gemb生物试剂br培养基教学仪器
图片尺寸600x800
上海博微 曙红琼脂培养基emb 实验室生化试剂 250g瓶
图片尺寸800x800
包发票发票环凯022060emb伊红美蓝琼脂培养基br250g化妆品教学仪器
图片尺寸1000x1000
大肠菌群 - 培养基 - 北京陆桥技术股份有限公司
图片尺寸671x675
生长大肠杆菌的emb培养基
图片尺寸220x165
伊红美蓝琼脂培养基emb
图片尺寸800x540
伊红美蓝(emb)琼脂无菌平皿 即用型培养基平板 90mm 10皿/包
图片尺寸800x800
培养基emb环凯微生物干粉022060伊红美蓝琼脂试剂
图片尺寸800x800
广东环凯 022060 伊红美蓝琼脂培养基emb 250g
图片尺寸1920x1920
emb培养基是什么培养基
图片尺寸883x653
emb培养基作为鉴别或选择培养基的原理
图片尺寸562x401
大肠菌群 - 培养基 - 北京陆桥技术股份有限公司
图片尺寸721x698
伊红美蓝琼脂培养基emb
图片尺寸800x800
伊红美蓝培养基emb的应用
图片尺寸350x284
emb培养基作为鉴别或选择培养基的原理
图片尺寸600x400
青岛emb伊红美蓝琼脂培养基大肠杆菌实验用微生物检测hb0107 伊红美蓝
图片尺寸800x800